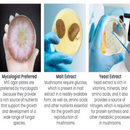
Horticulture Grow Mycology Olympus Myco Agar Uses

- Description
Description
Introducing our high-quality Agar Plates, specially designed for mycology enthusiasts and professionals alike! Our agar plates are sterile and ready to use, making them a convenient and reliable option for your fungal culturing needs.
Each plate is made of premium quality agar, ensuring consistent results and optimal growth conditions for a wide range of mycelium strains. Our plates are also free from contaminants, ensuring that your cultures remain pure and unaffected by unwanted microbes.
Our agar plates are easy to use, with a clear and durable plastic lid that allows you to observe the growth of your cultures without disrupting them. The plates are pre-poured, eliminating the need for messy and time-consuming preparation.
With our agar plates, you can focus on the fun part of mycology – experimenting and observing the fascinating world of fungi. Whether you are a beginner or an experienced mycologist, our agar plates are a must-have in your lab.
Order now and experience the convenience and reliability of our agar plates for yourself!
- PRE-POURED AGAR PLATES: The sterile plates are pre-poured MYA or malt yeast extract agar. Malt yeast extract agar plates are excellent for mushroom cultivation due to being a nutrient-rich medium that allows the cultivation of a wide spectrum of bacteria, yeasts, and molds.
- MUSHROOM MEDIA: These agar plates are made with a blend of ingredients to provide a nutritionally rich medium for your fungi and promote robust fungal growth. Yeast extract's proteins are broken down into simpler compounds for mycelium digestion.
- MOLD DETECTION: Malt Yeast Extract Agar Plates are suitable for the detection, isolation, and enumeration of fungi, particularly yeast, and molds.
- READY TO USE: Our pre-poured malt yeast extract agar plates are sterile and ready to use.
10 Sterile Pre-Poured Agar Plates